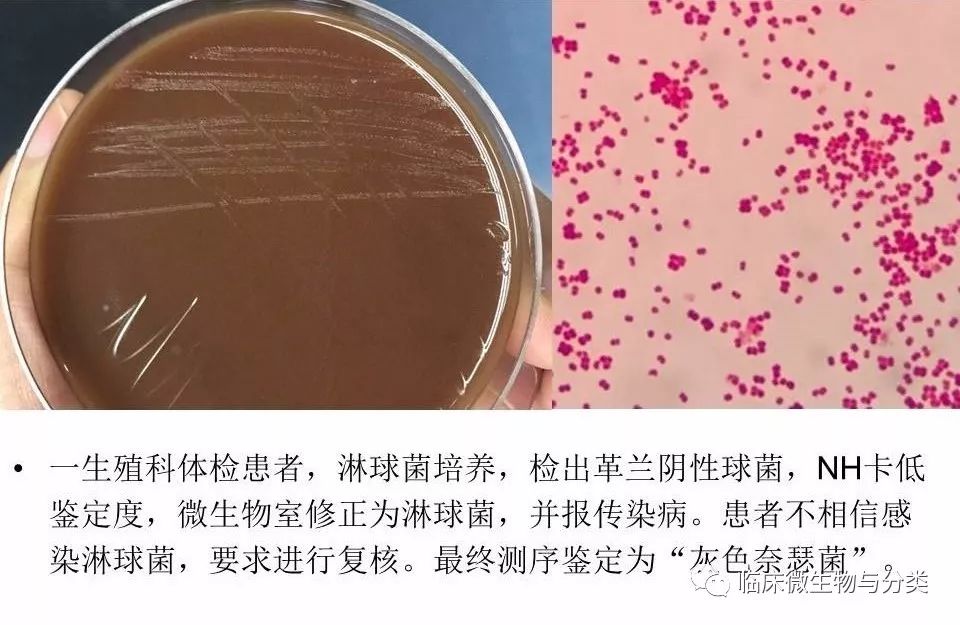

基因测序在临床菌种鉴定中的应用和案例分析
| 导读 | 目前,基因测序技术,已经成为临床不常见菌鉴定的一条重要捷径,以及指导和认识未知微生物世界的重要方法。本文在回顾基因测序技术发展历史的基础上,对基因测序在临床微生物菌种鉴定中的应用进行简要的介绍。 |
作者及单位
张 磊 广州金域医学检验中心 微生物室
屈平华 广东省中医院 检验科
在我们临床工作中,总会遇到那么一小部分细菌和真菌,采用现有的手段不能被鉴定(不在鉴定系统的数据库范围内),甚至找不到任何的鉴定思路和方向。
但随着分子生物学技术的发展,分子生物学技术在微生物的菌种鉴定中发挥着越来越重要作用。目前,基因测序技术,已经成为临床不常见菌鉴定的一条重要捷径,以及指导和认识未知微生物世界的重要方法。
本文在回顾基因测序技术发展历史的基础上,对基因测序在临床微生物菌种鉴定中的应用进行简要的介绍。

众所周知,1977年,Sanger发明了末端合成终止测序技术,并于1980年获得诺贝尔化学奖。需要说明的是,尽管DNA测序技术很了不起,但在最初,该技术并不好用。



PCR技术出现,解决了基因测序过程所需的时间问题;再然后,多色荧光标记和自动化检测技术的运用,解决了DNA测序过程中序列读取的难题。




















2015年,国内吴庆老师发现结核分枝杆菌在血平板上生长更快,最快的5天可以看见菌落,吴庆老师在专业微信群中把这个情况与老师们交流的时候,引来很多老师一片质疑声,纷纷要求把菌落送测序鉴定确认,我们检测的第一例结核分枝杆菌测序鉴定就是从这例开始,最后吴庆老师送来的几株血平板上生长的分枝杆菌都被测序鉴定确认为结核分枝杆菌,吴庆老师发现,其实验室所有检出结核分枝杆菌在血平板上7-14天均可形成肉眼可见菌落,与一些文献的结论一致(新观点:结核分枝杆菌在血平板上生长快速,最快5天形成菌落)。

淋病奈瑟菌和灰色奈瑟菌,一个是被认为是性传染性病原菌,另一个被认为是致病力较弱的定植菌,还是很有必要分清楚,测序鉴定可以搞定。






(转化医学网360zhyx.com)
 腾讯登录
腾讯登录
还没有人评论,赶快抢个沙发